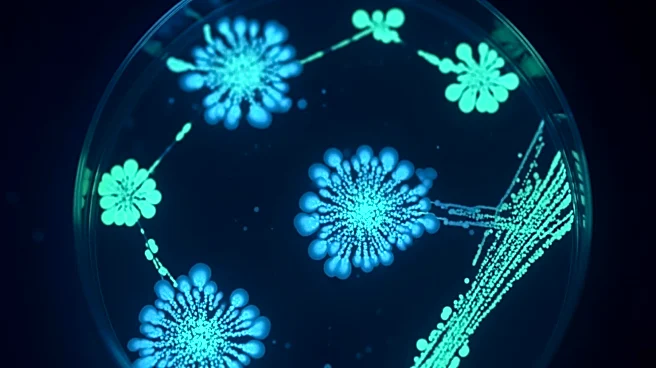
Researchers Discover Bacteria That Eradicates Tumors in Mice

What's Happening?
Researchers at the University of Chicago have discovered that zeaxanthin, a plant-based compound known for supporting eye health, can enhance the immune system's ability to fight cancer. The study, published in Cell Reports Medicine, found that zeaxanthin boosts
the activity of CD8+ T cells, which are crucial for identifying and destroying cancer cells. By stabilizing the T-cell receptor complex, zeaxanthin improves T-cell activation and cytokine production, leading to stronger anti-tumor responses. In mouse studies, zeaxanthin slowed tumor growth and enhanced the effectiveness of immune checkpoint inhibitors, a type of cancer immunotherapy.
Why It's Important?
This discovery suggests that zeaxanthin, a widely available and inexpensive supplement, could improve the efficacy of cancer immunotherapies. By enhancing the body's natural immune response, zeaxanthin could provide a complementary approach to existing cancer treatments, potentially improving outcomes for patients. The research highlights the broader significance of diet in immune health and suggests that specific nutrients can play a crucial role in supporting cancer treatment. This finding opens new avenues for nutritional immunology, exploring how dietary components interact with the immune system at a molecular level.
What's Next?
While the results are promising, further research is needed to confirm the effectiveness of zeaxanthin in human cancer patients. Clinical trials will be necessary to determine its potential as a complementary treatment in cancer care. Researchers will continue to explore the role of other dietary nutrients in enhancing immune responses, potentially leading to new strategies for improving cancer therapies. The study underscores the importance of integrating nutritional approaches into cancer treatment and could lead to more accessible and effective therapies.